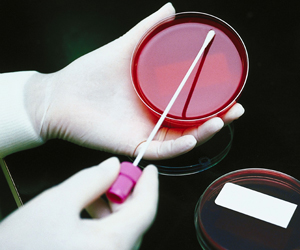

Appeals Court clarifies application of UCC in Sizzler case
By Deborah Spanic, legal writer
June 15, 2011 – The District I Wisconsin Court of Appeals has clarified the law around the application of Wisconsin’s Uniform Commercial Code (UCC) and implied warranties in Estate of Brianna Kriefall v. Sizzler USA Franchise et. al., 2009AP1212 (June 7, 2011).
This is one of a series of cases brought as a result of several deaths and illnesses from an outbreak of E. coli bacteria at several Sizzler restaurants in the Milwaukee area in 2000. Sizzler USA Franchise, Inc. (“Sizzler USA”) is the franchisor of the Sizzler restaurants. E&B Management Co. (“E&B”) was the franchisee of the Milwaukee-area Sizzler restaurants affected by the E. coli outbreak.
Excel Corporation (“Excel”) is the packer and seller of the meat that was contaminated by E. coli and provided to the Sizzler restaurants. The Kriefalls and other plaintiffs settled. This appeal concerns disputes between the Sizzler companies and Excel, primarily relating to indemnification.
At trial, the jury found that Excel breached an “implied warranty of merchantability or implied warranty for the sale of food,” that Excel’s breach was a “cause of damage” to Sizzler USA, and as a result, Sizzler USA was entitled to $6.5 million for lost profits, $350,000 for lost franchise royalties and $311,000 for out of pocket expenses. See Kriefall, ¶ 3.
The jury also found that Excel’s negligence in selling contaminated meat was a “cause of injuries to the patrons of the two E&B Sizzler restaurants, that Excel was negligent at the time of the E. coli outbreak, and that in apportioning causal negligence, Excel was 80 percent causally negligent and E&B was 20 percent causally negligent. See Id.
Claims and cross-claims for liability under express and implied warranty
Excel appealed the finding that it is liable for consequential damages to Sizzler USA under implied warranty. Sizzler USA cross-claimed and sought damages that resulted from Excel’s breach of Excel’s express warranty that its meat would be wholesome and safe, and that Excel breached its implied warranties that its meat was merchantable, fit to be used in Sizzler restaurants and was “safe and fit for human consumption.” See Id., ¶ 7.
The express warranty claim was based on a “Continuing Guaranty” document between Excel and Sizzler International, Inc. (the parent company of Sizzler USA), which stated that each shipment was guaranteed to be “Not adulterated … within the meaning of the Federal Food, Drug and Cosmetic Act ….” The Continuing Guaranty also explicitly disclaimed “any incidental or consequential damages.” See Id., ¶ 8.
On summary judgment, the trial court held that Excel’s liability for consequential damages were specifically excluded by the Continuing Guaranty, and dismissed Sizzler USA’s express warranty claim, but the trial court also held that the disclaimer did not affect Excel’s duties under the implied warranty provisions of Wisconsin’s Uniform Commercial Code (Wis. Stat section 402.314) or Sizzler USA’s remedies under the Code.
Section 402.314 states that, “Unless excluded or modified, a warranty that the goods shall be merchantable is implied in a contract for their sale if the seller is a merchant with respect to goods of that kind.” See Id., ¶¶ 8-9.
Excel claimed that the clause in the Continuing Guaranty that expressly disclaimed consequential damages removed consequential damages from the implied warranties as well. The Appeals Court disagreed, noting that the phrase in the Continuing Guaranty excluded the right of Sizzler USA to recover consequential damages encompassed only the express warranties undertaken by the Continuing Guaranty. The court clarified, “Incidental and consequential damages are excluded from those damages that might be recovered if the express warranties in the Continuing Guaranty were breached.” See Id., ¶¶ 12-13.
To put it another way, the court confirmed that the incidental and consequential damages limitation in the Continuing Guaranty applies only to a breach of express warranties created by that agreement, and “thus the limitation did not extend beyond the four corners of the Continuing Guarantee. See Id., ¶ 16.
As Excel’s delivery of contaminated meat to the E&B Sizzler restaurants breached implied warranties recognized under Wisconsin’s Uniform Commercial Code statutes, and Excel had put nothing in any written agreements to exclude or modify the implied warranty of merchantability, the appeals court held that the trial court did not err in awarding Sizzler USA damages for Excel’s breach of implied warranty. See Id., ¶¶ 15, 17, 23.
Remaining issues in the case
The court of appeals also decided a number of other claims and cross-claims among the parties, including issues related to indemnification on Pierringer releases, evidentiary issues related to expert testimony at trial, and contribution claims. In all, the Court of Appeals affirmed the trial court’s judgments and orders except it reversed the trial court’s order permitting E&B to recover from Excel money Federal Insurance paid to Secura (E&B’s insurance company), and also reversed the trial court’s order rejecting Sizzler USA’s equitable indemnity claim against Excel.
